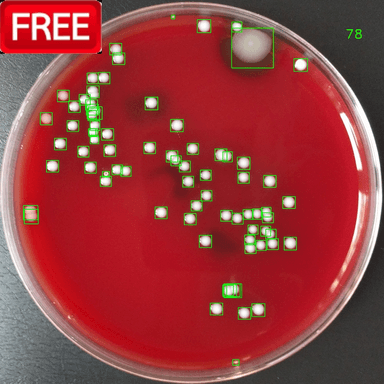

This app streamlines antimicrobial testing by automating the measurement of inhibition zones on Petri dishes. It analyzes images to determine areas where bacterial growth is inhibited, delivering fast and reliable results. Designed for microbiologists and researchers, the app enhances accuracy and efficiency in lab and research settings. Intended for Research Use Only (RUO).

BiTTE lite is a simplified version of the BiTTE product, designed for easy and efficient detection of microorganisms in various applications. It focuses on the classification of microorganisms into seven categories: Gram-negative rods (GNR), Gram-negative cocci (GNC), Gram-positive rods (GPR), Gram-positive cocci (GPC), yeast-like fungi (Yeast), no bacteria and the combination of them. Intended for Research Use Only (RUO).
Free for the first 14 days

This app (Nugent Score AI 1.0) is a support tool designed to assist microbiologists, researchers, and laboratories in evaluating Nugent scores efficiently. Leveraging AI technology, the app simplifies the analysis of Gram-stained images taken with a C-mount camera through a microscope, improving diagnostic consistency and accuracy. This tool enhances the workflow for professionals in microbial analysis, serving as an aid rather than a diagnostic device. Intended for Research Use Only (RUO).
Free for the first 14 days

BM Smear AI 1.0 is an AI-powered research tool designed to automate the classification of bone marrow smear samples. Trained on a large dataset of images captured using the CELLAVISION DC-1, this tool utilizes deep learning algorithms to efficiently detect and classify various bone marrow cell types. Intended for Research Use Only (RUO)
Free for the first 14 days

This app streamlines antimicrobial testing by automating the measurement of inhibition zones on Petri dishes and SIR (Sensitive, Intermediate, Resistant) results. Intended for Research Use Only (RUO).
Free for the first 14 days
ZOI VET is designed for use in veterinary microbiology and automates the Zone of Inhibition (ZOI) measurement process for antimicrobial susceptibility testing (AST). The app detects and measures inhibition zones from Petri dish images and determines susceptibility results—Sensitive, Intermediate, or Resistant (S/I/R)—based on the selected bacterial strain and antibiotic. The SIR result is used the criteria CLSI VET01S ED7:2024 – Performance Standards for Antimicrobial Disk and Dilution Susceptibility Tests for Bacteria Isolated From Animals published by the Clinical and Laboratory Standards Institute (CLSI). This tool helps laboratories reduce manual workload, improve standardization, and enhance result accuracy. ZOI VET is intended for Research Use Only (RUO).
Free for the first 14 days
Automatically detects and counts bacterial colonies from agar plate images. Returns total count and bounding boxes, with optional annotated output. Designed for food-industry QC and research. RUO.